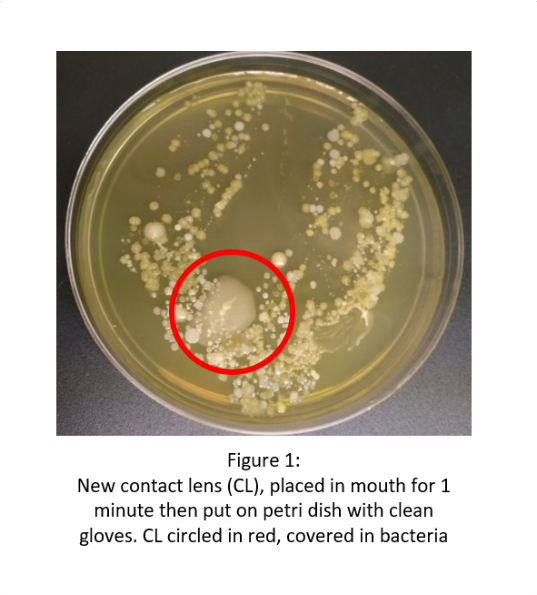
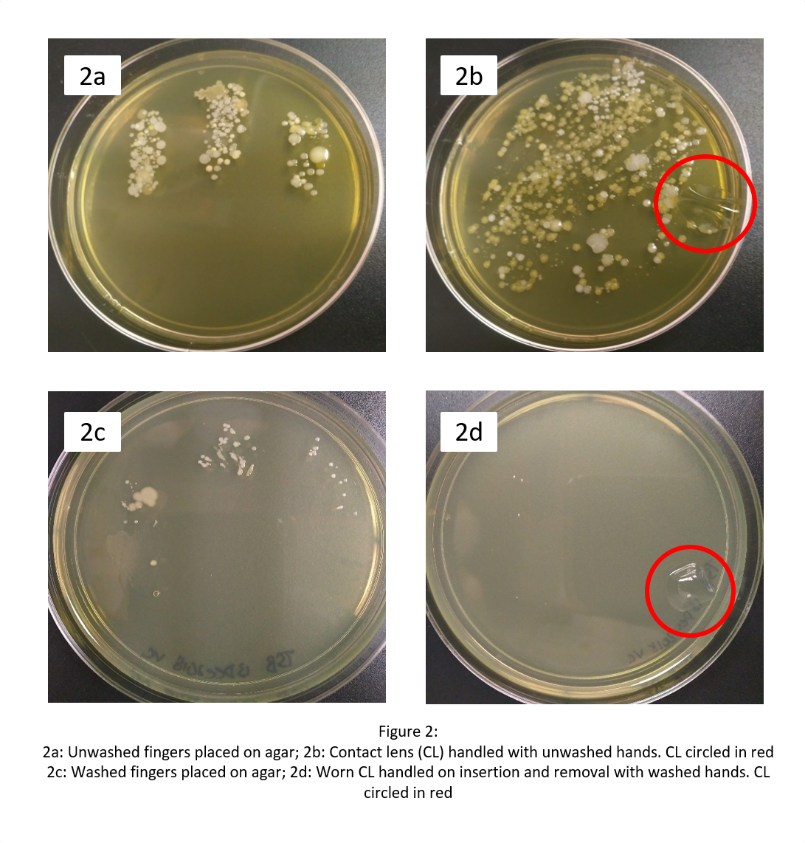

Importance of contact lens hygiene
Caught short without your contact lens case or care solutions? Lens unexpectedly falls out? What would you do? NBA star Ron Baker, faced with just this dilemma earlier this year chose to pop his lens in his mouth to wet it and then place it back on his eye. This was seen by countless people around the world as the video clip spread online, eliciting cringes from the eye health community and shrugs from wearers who have done the same.
 During the holidays, when routines are disrupted and time is at a premium, contact lens wearers may also be tempted to skip regular hygiene practices. But is it wise? Scientists from the Centre for Ocular Research & Education (CORE) at the University of Waterloo conducted an eye-popping experiment to help consumers picture the risks.
During the holidays, when routines are disrupted and time is at a premium, contact lens wearers may also be tempted to skip regular hygiene practices. But is it wise? Scientists from the Centre for Ocular Research & Education (CORE) at the University of Waterloo conducted an eye-popping experiment to help consumers picture the risks.
To demonstrate the rapid growth of bacteria associated with mishandling contact lenses, CORE researchers exposed new, clean contact lenses to human saliva and then placed them into petri plates for monitoring. The action of putting a contact lens in the mouth resulted in significant growth of microorganisms after only two days of incubation (Figure 1).
They then examined the effect of handling contact lenses with both clean and unwashed hands. Unwashed hands were pressed into agar (Figure 2a), and also used to handle a new contact lens (Figure 2b). Scientists then repeated the procedure after following recommended handwashing practices, touching both the agar directly, along with applying and  removing a contact lens (Figures 2c and 2d). The results clearly demonstrate the impact handling has on contact lenses. Samples that had been placed in the mouth or touched with unwashed hands showed significantly higher numbers of visible bacteria. By comparison, the contact lens touched with clean hands had only a minimal bacterial load.
removing a contact lens (Figures 2c and 2d). The results clearly demonstrate the impact handling has on contact lenses. Samples that had been placed in the mouth or touched with unwashed hands showed significantly higher numbers of visible bacteria. By comparison, the contact lens touched with clean hands had only a minimal bacterial load.
removing a contact lens (Figures 2c and 2d). The results clearly demonstrate the impact handling has on contact lenses. Samples that had been placed in the mouth or touched with unwashed hands showed significantly higher numbers of visible bacteria. By comparison, the contact lens touched with clean hands had only a minimal bacterial load.
removing a contact lens (Figures 2c and 2d). The results clearly demonstrate the impact handling has on contact lenses. Samples that had been placed in the mouth or touched with unwashed hands showed significantly higher numbers of visible bacteria. By comparison, the contact lens touched with clean hands had only a minimal bacterial load.
“Contact lenses are a safe, highly effective form of vision correction used by millions of people, but ignoring good contact lens care can have a devastating effect on eye health and vision,” says CORE senior research associate Miriam Heynen, MSc, who conducted the experiment with laboratory research assistant Vivian Chan, Bsc., after hearing a news report on poor contact lens care habits.
She continued, “Bacteria are present on surfaces all around us and this simple experiment is a graphic demonstration of how they reproduce over just a short amount of time. Taking care of your contact lenses is a must, no matter how pressed for time you are. Handle with clean, dry hands, use a case and care solution as recommended by an eye care practitioner, and always keep spare contact lenses and spectacles with you. Proper care is simple, essential for good health, and after seeing these photos, a no-brainer for anyone who appreciates their eyes.”
Contact lens wearers can more easily resolve to practice better hygiene during the holiday season and the New Year, thanks to a printable, easy-to-read tip sheet available from CORE which covers good hand hygiene along with other reminders on safe contact lens wear


No comments:
Post a Comment